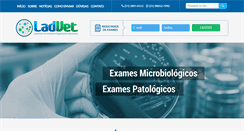
Desktop Preview

ladveri.ru
ladveri.ru
Двери Иркутск: продажа дверей в Иркутске, установка дверей от магазина Ладвери
Один из магазинов нашей сети. ТЦ Парус, Трактовая, 35. Это качество и сервис высокого уровня с момента первого взгляда на каталог до финального поворота ключа в замке Вашей новой двери. Межкомнатные и входные двери от десяти отечественных компаний-производителей;. Продажа дверей (Иркутск, Ангарск);. Возможность заказать нестандартные изделия;. Оперативная доставка и качественная установка дверей (Иркутск);. Гарантия производителя и установщиков;. Сочетание доступных цен и гибкой системы скидок. Буревестн...
 ladvertie.weebly.com
ladvertie.weebly.com
Pubons ensemble - Pubathon
Contacter la tite advertie. Glamour, humour ou juste lourd. Dommage d'en arriver à un résultat navrant et dégradant parce que l'idée de base était plutôt amusante. Avec une voix de femme indépendante, qui assume ce qu'elle fait, l'humour aurait pu passer. Plaisanterie s'est juste transformée en grosse connerie lors de l'étape réalisation. Il ne devrait y avoir que des hommes dans l'équipe pour laisser passer un truc comme ça. Ils se voulait décalés. Ils se sont auto sacagés oui! Du duo néerlandais Weval.
 ladvertising.it
ladvertising.it
Ladvertising – Comunicazione è vita.
Mostra o nascondi la navigazione. Laboratorio di Advertising e comunicazione. Gli esperti di comunicazione al tuo servizio. Il tuo ufficio comunicazione in outsurcing. Un ufficio di comunicazione al vostro servizio, composto da professionisti del mondo digital e dell’advertising tradizionale. Gestione delle pagine social aziendali e realizzazione di campagne pubblicitarie. Grazie all’utilizzo di piattaforme pubbliche di contest gestione al meglio le creatività per le vostre campagne. Su tutti i mezzi.
 ladvertising.org
ladvertising.org
Ladvertising
Lorem ipsum dolor sit amet. Fusce scelerisque odio non dignissim convallis. Donec vehicula nisl nec odio pretium, auctor fermentum neque congue. In vel varius justo. Duis sed erat sit amet purus condimentum sollicitudin. We’re Alma, a WordPress Theme. We have created a new product that will help designers, developers and companies create websites for their startups quickly and easily. Etiam varius, orci in rhoncus rutrum, purus ligula mattis justo lorem ipsum dolor sit. LADVERTISING HAS SO FAR PROVIDED.
 ladvertising.wordpress.com
ladvertising.wordpress.com
Confessions of a Ladman | A comprehensive collection of all things ladvertising. If you’re not sure what that means you probably shouldn’t be here.
Confessions of a Ladman. A comprehensive collection of all things ladvertising. If you’re not sure what that means you probably shouldn’t be here. Skip to primary content. Skip to secondary content. Bulmers 17 – Experimenters wanted. I love this current Bulmers campaign. The premis is simple Bulmers, who I would imagine have a pretty decent share of the Cider market, are launching a new product line apple cider with red berries and lime. Boycott – lad. Http:/ www.bbc.co.uk/programmes/p00jjlt7. 2 In a wor...
 ladvet.com
ladvet.com
LadVet | Laboratório de Análises e Diagnósticos Veterinários
Selecione a Área de Interesse. Confiança e Eficiência ao seu alcance. O LADVET é um laboratório destinado a realizar, com rapidez e precisão, exames clínicos veterinários, com o objetivo de ajudá-los a chegar, de maneira eficaz. Saiba como enviar cada tipo de amostra para nossa laboratório. Hemograma, Bioquímica Sérica, Urina, Fezes, Líquidos Cavitários, Raspado de Pele e Citologia. Notícias e Artigos veja mais. 5 motivos para se preocupar com a mastite no seu rebanho. Desenvolvido por Redline Websites.
 ladvez.net
ladvez.net
Фотоальбомы | Ладвезы
Dock на рабочем столе. Коды http ошибок веб-сервера. Всё на передний план. I'm sorry to inform you that your browser don't support CSS3 Animations! This site uses features that. A modern browser - why not try Firefox. Инновационный Рабочий стол Macintosh. Finder версия 10.9.5. TM and 1983-2013 Apple Inc. Версия 10.9.5. 2 Ghz Intel Core 2 Duo. 4 GB 1067 Mhz DDR3. TM and 1983-2013 Apple Inc. This application cannot be used in this version.
 ladvf.6te.net
ladvf.6te.net
LadvF - Liga Acadêmica de Doenças Vasculares da FAG
169; 2011 Todos os direitos reservados. Liga de Doenças Vasculares da FAG. Desenvolvimento técnico do Site: LadvF. LIGA ACADÊMICA DE DOENÇAS VASCULARES DA FAG.
 ladvi-land.blogspot.com
ladvi-land.blogspot.com
Ladvi Land
Sâmbătă, 11 decembrie 2010. Abonați-vă la: Postări (Atom). Bine ati venit in Ladvi Land! Au nevoie de dragostea voastra. Reina, cățelușă de pază pt adopție. Muffin – o minunatie de motan – de adoptat si de iubit pentru toata viata, Bucuresti. Asociatia Phoenix - animal protection and human care - adoptii caini si pisici. De ce unele femei isi pot pastra silueta? 7 intr-o saptamana #160. 10 motive pentru care nu trebuie sa ratezi DETOX market. 3 link-uri pentru Duminica {15.05}. Magazine de haine online.
 ladvi.com
ladvi.com
ladvi.com - This website is for sale! - ladvi Resources and Information.
The domain ladvi.com. May be for sale by its owner! This page provided to the domain owner free. By Sedo's Domain Parking. Disclaimer: Domain owner and Sedo maintain no relationship with third party advertisers. Reference to any specific service or trade mark is not controlled by Sedo or domain owner and does not constitute or imply its association, endorsement or recommendation.
 ladvi.cz
ladvi.cz
Galerie LÁDVÍ
Moto: Žít a nechat žít, dívat se a zaznamenávat. Krajina, památky, detail, portrét,. Těhotná žena, žena a dítě, glamour a akt. Umění, obrazy, fotografie, památky. A zajímavé události v Praze 8 a okolí. Krajiny domova - Pavel Poličanský. Expedice Monte Negro 2009. Aerobic Báry a Hanky Šulcové 2014. Reportáže v rodině a u přátel. Fotograf, galerista - Petr Pokorný Ing. alias peposoft. Modifikováno dne 17/04/14 14:51. Galerista, webmaster peposoft@volny.cz. Optimalizováno pro IE a rozliš. 1280 x 1024.